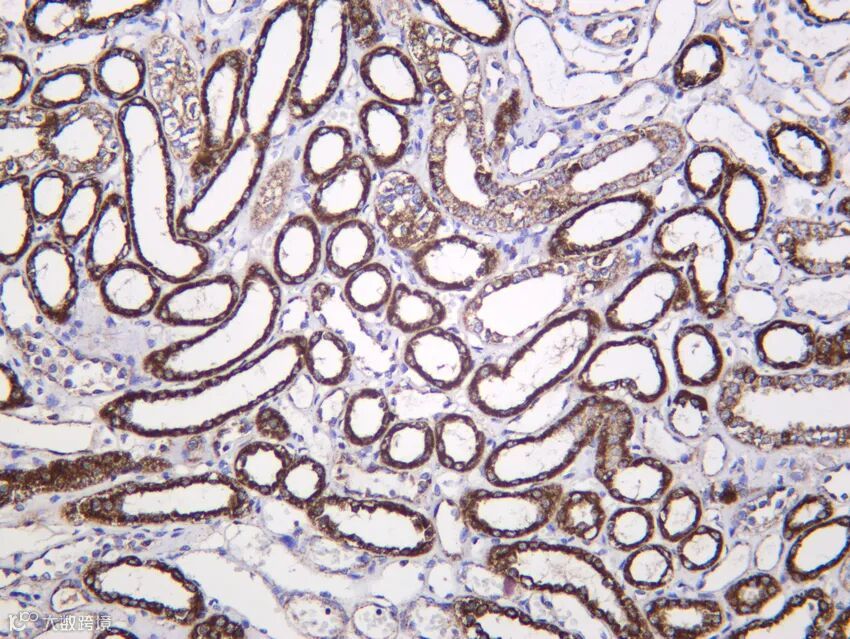
5fb4206e06a0636b8a1d6e69bef3948e_RX2093-PT1744R-Human%20kidney.jpg

Immunoway的兔重组基因工程抗体——PT™ Rabbit mAb 研发平台拥有四重特异性筛选环节,以确保抗体的高度特异性和高亲和力。
首先用特异性多肽或者真核蛋白对兔子进行免疫,刺激其免疫系统产生特异性抗体,抽取血液做内源性样本的特异性检测和血清效价的检测;
在B细胞筛选过程中,通过双阳性流式细胞分选,分离出B细胞表面IgG+和抗原特异性+的B细胞;
然后对单B细胞进行培养,并通过Elisa、IHC、WB、IF等实验对阳性B细胞进一步进行特异性筛选鉴定;
将筛选出的B细胞中的抗体可变区基因进行克隆与重组,将重组抗体基因导入哺乳动物细胞中进行表达,再通过如Elisa、WB、IHC、IF、FCM、IP等全面特异性验证方式进行检测;
最后通过细胞培养、抗体表达和纯化等步骤,获得高纯度的兔重组基因工程抗体。

Rab10 (PT1212R) PT™ Rabbit mAb
Reactivity:Human, Mouse, Rat
Applications:WB, IF, IP, ELISA

关键词:小GTP酶、囊泡 trafficking、GLUT4转位
Rab10 是 Rab GTP 酶家族成员,在胰岛素刺激下被激活,调控 GLUT4 储存囊泡向质膜的转运,促进葡萄糖摄取。此外,Rab10 参与初级纤毛形成、自噬体成熟及上皮极性建立。其功能受 DENND4C GEF 和 TBC1D1 GAP 精确调控。Rab10 异常与 2 型糖尿病、纤毛病相关。本抗体跨物种适用,支持 IP 验证互作,是膜运输与代谢研究的重要工具。

FMR1 (PT1226R) PT™ Rabbit mAb
Reactivity:Human, Mouse, Rat
Applications:WB, IHC, IF, ELISA

关键词:脆性X智力低下蛋白、mRNA翻译抑制、神经突触可塑性
FMR1 编码 FMRP(Fragile X Mental Retardation Protein),一种 RNA 结合蛋白,通过结合靶 mRNA(如 PSD-95、MAP1B)抑制其在突触局部的翻译,调控树突发育与可塑性。CGG 重复扩增导致 FMR1 启动子甲基化沉默,引发脆性 X 综合征(最常见遗传性智力障碍)。FMRP 还参与 DNA 损伤响应。本抗体跨物种识别 FMRP,适用于脑组织 IHC 和 IF,是神经发育疾病研究的核心工具。

Flotillin-2 (PT1253R) PT™ Rabbit mAb
Reactivity:Human, Mouse, Rat
Applications:WB, IF, IP, ELISA

关键词:脂筏标志物、膜微区、信号平台
Flotillin-2 与 Flotillin-1 形成异源寡聚体,定位于质膜脂筏(lipid rafts),作为信号分子(如 EGFR、TGFβR)的组织平台,调控内吞、细胞迁移及神经元轴突生长。其在肿瘤中常高表达,促进侵袭;也可作为外泌体标志物。Flotillin-2 磷酸化状态反映膜动力学活性。本抗体跨物种适用,支持 IP 验证脂筏复合物,是膜生物学与肿瘤转移研究的基础工具。

hnRNP Q (PT1738R) PT™ Rabbit mAb
Reactivity:Human, Mouse, Rat
Applications:WB, IHC, IF, ELISA


关键词:RNA结合蛋白、mRNA稳定性、翻译调控
hnRNP Q(Synaptotagmin-binding cytoplasmic RNA-interacting protein, SYNCRIP)参与 mRNA 剪接、转运、稳定性和 IRES 介导的翻译起始,调控 MYC、p53 等关键基因表达。在神经元中,它影响突触蛋白局部翻译;在病毒感染中被劫持以促进病毒复制。hnRNP Q 异常与神经退行性疾病相关。本抗体跨物种适用,适用于核质分布分析,是 RNA 代谢研究的重要工具。

FH (PT1744R) PT™ Rabbit mAb
Reactivity:Human, Mouse, Rat
Applications:WB, IHC, IF, IP, ELISA

关键词:延胡索酸水合酶、三羧酸循环、遗传性平滑肌瘤病
FH(Fumarate Hydratase)是线粒体 TCA 循环酶,催化延胡索酸水合生成苹果酸。种系突变导致遗传性平滑肌瘤病和肾细胞癌(HLRCC),因延胡索酸积累抑制 PHD,稳定 HIF-1α,模拟缺氧。FH 也是潜在的肿瘤抑制因子。本抗体跨物种识别 FH,支持 IP 验证酶复合物,是代谢重编程与遗传性癌症研究的关键工具。

CD69 (PT1700R) PT™ Rabbit mAb
Reactivity:Human
Applications:WB, IHC, IF, IP, ELISA


关键词:早期活化标志物、淋巴细胞激活、组织驻留
CD69 是 C 型凝集素受体,在 T、B、NK 细胞活化后数小时内表达,抑制 S1P1 介导的淋巴细胞外流,促进组织驻留。它是肿瘤浸润淋巴细胞(TILs)和组织驻留记忆 T 细胞(TRM)的关键标志物。CD69 还具有免疫调节功能。本抗体特异性识别人源 CD69,适用于 IHC/IF 鉴定早期免疫应答,是肿瘤免疫与疫苗研究的重要工具。

新品速递

| 货号 | 名称 | 规格 |
SMARCC1 (PT1242R) PT™ Rabbit mAb |
40μL/100μL/200μL |
|
SMCA5 (PT1257R) PT™ Rabbit mAb |
40μL/100μL/200μL |
|
SHP-2 (Phospho Tyr542) (PT1271R) PT™ Rabbit mAb |
40μL/100μL/200μL |
|
ApoER2 (PT1689R) PT™ Rabbit mAb |
40μL/100μL/200μL |
|
CD1d (PT1703R) PT™ Rabbit mAb |
40μL/100μL/200μL |
|
SLAM (PT1712R) PT™ Rabbit mAb |
40μL/100μL/200μL |
|
MEF-2 (PT1725R) PT™ Rabbit mAb |
40μL/100μL/200μL |
|
BTF (PT1726R) PT™ Rabbit mAb |
40μL/100μL/200μL |
|
CD166 (PT1737R) PT™ Rabbit mAb |
40μL/100μL/200μL |
|
Myoglobin (PT1739R) PT™ Rabbit mAb |
40μL/100μL/200μL |
|
TCF-4 (PT1740R) PT™ Rabbit mAb |
40μL/100μL/200μL |
|
AF-10 (PT1742R) PT™ Rabbit mAb |
40μL/100μL/200μL |
|
M-CSF (PT1745R) PT™ Rabbit mAb |
40μL/100μL/200μL |
|
Pin1 (PT1743R) PT™ Rabbit mAb |
40μL/100μL/200μL |
|
S100P (PT1648R) PT™ Rabbit mAb |
40μL/100μL/200μL |
|
E2F-2 (PT1711R) PT™ Rabbit mAb |
40μL/100μL/200μL |
|
DHODH (PT1731R) PT™ Rabbit mAb |
40μL/100μL/200μL |
- END -
About
关于睿捷生物科技有限公司
睿捷生物科技有限公司是 (realgen-bio Co., Ltd.,简称睿捷生物)致力于为国内生命科学领域提供先进、专业的仪器设备、试剂耗材的企业。公司目前是近20家国内外知名生物公司的一级代理商,为客户提供从研发到生产的各类实验室仪器,检测试剂和生产设备。
公司产品领域涵盖分子生物学、免疫学、血液学、肿瘤研究、信号通路、药物筛选、干细胞研究、神经生物学、表观遗传学等等,为用户提供系统性的科学研究完整解决方案,成为众多研究者们可以信赖的选择。
公司成立于2011年,总部位于苏州,在南京、济南、合肥都设有办事处,公司客户主要为国内领先的生物制药、细胞治疗、生物医学和各类生物技术公司,以及大量的生命科学基础研究和政府实验室,目前已服务客户单位4000余家。

睿捷-企业文化
公司的使命:高效服务客户、为客户持续创造价值
公司的愿景:将人与科技相结合,成为生命科学领域一流的解决方案供应商
公司的价值观:诚信、公开、坚持、分享
睿捷-合作伙伴













